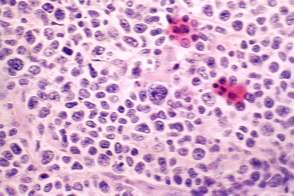

Thyroid cancers - case 630 |
|
Clinical presentation: A 92-year-old woman has been treated for hypothyroidism for 3 years. Relatives noticed 6 months ago that the patient’s thyroid gland began to grow.. At the time of the investigation, the patient hasn't been able to swallow solid foods for 10 days.
Palpation: a large, hard tumor in the left lobe.
Functional state: euthyroidism on daily 75 microgram levothyroxine (TSH-level 3.08 mIU/L).
Ultrasonography. The right lobe was hypoechogenic and was not enlarged. The pattern in this lobe corresponded to Hashimoto's thyroiditis. There was a huge tumor in the left thyroid. The pattern of the left lobe varied from moderate to severe hypoechogenicity. The tumor was avascular.
Cytology: suspicion of non Hodgkin' lymphoma.
Biopsy was performed from the left thyroid and histopathology revealed MALT-type non Hodgkin lymphoma.
Follow-up. The patient responded very well to chemotherapy. She was able to swallow on his own within a week. From a thyroid point of view, she lived without complaints for another three years when she died of terminal weakness.